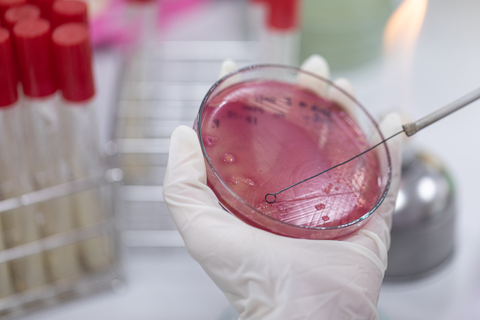

Data Structure
Networking
RDBMS
Operating System
Java
MS Excel
iOS
HTML
CSS
Android
Python
C Programming
C++
C#
MongoDB
MySQL
Javascript
PHP
- Selected Reading
- UPSC IAS Exams Notes
- Developer's Best Practices
- Questions and Answers
- Effective Resume Writing
- HR Interview Questions
- Computer Glossary
- Who is Who
What Are the Different Isolation and Screening Techniques?
Introduction
Isolation is a process of separating individual bacteria to study their morphology or for industrial purposes.
The process of isolating and screening a microbe out of natural surroundings, such as soil, which has a substantial microbial population, is a costly and lengthy process. For instance, Eli Lilly & Co. Ltd., after screening 4,00,000 organisms, identified three main types of microbes that produce antibiotics over the course of ten years.
Streaking is a method used in microbiology to isolate a pure strain from a single species of microbe, frequently a bacterium. In order to identify, research, or test the organism, samples can be obtained from the resulting colonies and a microbiological culture can be produced on a new plate.

As Robert Koch and other microbiologists sought bacterial microbiological cultures in order to investigate them, the contemporary streak plate approach has advanced. First devised by Loeffler and Gaffky at Koch's lab, the dilution or isolation by streaking procedure includes systematically streaking bacteria over the surface of the agar in a Petri dish to create isolated colonies that would later expand into large numbers of cells or isolated colonies.
Isolation
In order to identify the microbe(s) of interest, a strain is separated from a natural, mixed population of living organisms found in the environment i.e., water or soil, or from living things skin, mouth, or gut flora.
Streaking and pour plating are the two techniques that are widely used for the isolation of bacteria.
Streaking
Streaking is a quick and, ideally, straightforward isolation dilution technique.
Method or procedure to be followed
- The method involves reducing the bacterial population from a relatively high concentration to a lower concentration.
- Bacterial decline should indicate that colonies are adequately spaced apart to influence the separation of the various microbe kinds. Streaking is done with a clean implement, usually an inoculation loop or a cotton swab.
- Microbiological cultures are kept up-to-date using aseptic procedures, which also help to keep the growing media clean.
- The process of streaking a plate can be done in a variety of ways. The technique chosen depends on personal choice as well as the number of microorganisms present in the sample.
- The T-Streak, a three-phase streaking pattern, First, a flame is used to sterilize the inoculation loop.
- The loop is dipped into an inoculum, such as a broth or patient specimen, that contains a variety of bacterial species when it is cool.
- After that, the inoculation loop is moved in a zigzag pattern across the agar surface until around 30% of the plate has been covered. The plate is then rotated 90 degrees while the loop is re-sterilized.
- The loop is pulled through the area that had previously been streaked two to three times to continue the zigzag pattern.
- The process is then carried out one more, being careful not to touch the areas that had previously been streaked.
Pour Plating
For obligate and anaerobic microorganisms, the pour plate method is a typical plating technique.

Method or Procedure to be Followed
- This method involves serial dilution, counting the colony-forming units, and is used to isolate microbial colonies (CFUs).
- In this procedure, the liquid sample is added to the petri dish before the agar medium has a chance to set.
- Colonies develop inside and outside of the medium after solidification. Confluent colonies, however, are growing within the medium; the colonies on the surface are counted as viable.
- Before handling any microbiological solution, wash your hands with an antiseptic solution.
- Any pertinent details, including your name, the date, the media you used, and the culture being injected, should be written on the petri dish.
- It can be suspended in sterilized broth or water to create a liquid solution. If the material is already liquid, prepare successive dilutions of it to reduce the concentration of microbial colonies, which should not exceed 20-300 CFU/ml. Dilutions up to 10-10 can be made.
- Open the Petri dish covers and add 1 cc of the diluted sample for inoculation. 15 to 18 ml of the molten agar should be poured onto the sample once it has been slightly heated.
Pour Plate Method Uses
Scientists use it to calculate the concentration of cells in a given sample and to obtain microbial growth curves.
It is also used to examine the impact of various environmental and growth factors on the rate of bacterial growth.
Screening
Screening is the process of finding and isolating a microbe from a natural environment, such as soil, which has a substantial microbial population. It is an expensive and time-consuming process.
Primary Screening of Microorganisms
Primary screening can be described as the qualitative ability of the desired microorganism to create the desired product, such as an antibiotic, amino acid, or enzyme, etc., followed by the detection and isolation of the desired microbe.
Secondary Screening Microorganisms
Secondary screening provides a wealth of relevant information, like newly isolated microbes in fermentation processes with economic value. These preliminary examinations are carried out in flasks or tiny fermenters filled with liquid media, or in petri dishes with solid media.
The liquid medium method is more accurate than the agar plate method because it offers more meaningful data regarding an organism's dietary, physical, and production responses to genuine fermentation production settings.
Primary and Secondary Screening Techniques
Following are the screening techniques used widely in primary and secondary screening
The Crowded Plate Technique
This primary screening method aids in identifying the microorganisms that can produce antibiotics or not. With the assistance of natural substrates, such as soil or other sources It is decided to use an "appropriate aliquot" of "serial dilution" that, when plated on an agar plate (also known as a crowded plate), can result in 300 to 400 colonies.
Indicator Dye Technique
Calcium carbonate is introduced into the portion of the agar medium in this indicator dye procedure. As a result, this method can be used to pinpoint the area of organic acid synthesis and identify colonies that are producing the substance. pH can be measured by adding "pH indicator dyes" like neutral red or bromothymol blue to "nutrient agar medium.
Enrichment Culture Technique
In general, it is a technique that aids in the isolation of the soil sample's relatively few microorganisms, which may have nutrient requirements that are crucial for industrial use. Several secondary procedures might be used to find out crucial information about the product or microorganisms.
Giant Colony Technique, Filtration Method, and Liquid Medium Method are a few examples of the numerous secondary screening processes.
Giant Colony Technique
The antibiotics that can diffuse through a solid medium are identified utilizing this method. This approach makes advantage of Streptomyces species, which can manufacture antibiotics during primary screening.
Filtration Method
This is a crucial technique that aids in testing the ineffective antibiotics that are water-soluble and cannot permeate across a solid media. A variety of antibiotic dilutions are made and added to molten "agar plating medium" as well to solidify.
Liquid Medium Method
It is a distinct kind of secondary screening technique that aids in figuring out how many antibiotic-producing bacteria, like Streptomyces, are actually isolated.
Conclusion
The microbiology of an organism or desired cells can be determined using either these primary or secondary methods. A straightforward methodology can be used to isolate and detect microorganisms in addition to the fundamental method.
As a result, it is a very useful procedure that can readily identify the biochemical traits that are displayed in bacteria and all of the crucial information about the chosen microbes can be discovered through secondary screening.